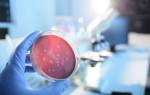

Эндометриоз — гинекологическое заболевание, вызванное появлением клеток эндометрия (эпителия, выстилающего полость матки) в нетипичных для него местах. Эндометриоидные имплантаты могут начать расти в маточных трубах, яичниках, мышечном слое матки (аденомиоз), прямой кишке, мочевом пузыре, брюшине и т.д. Особенностью этих имплантатов является проявление присущих эндометрию матки менструальных свойств, сопровождающееся образованием кист с кровянистым содержимым. При хроническом течении болезни возможно образование спаек, кист и рубцов, что приводит к непроходимости маточных труб и бесплодию.
У большинства женщин с эндометриозом матки или яичников овуляция не происходит, несмотря на менструацию.
Формы эндометриоза
В зависимости от локализации очагов эндометриоза выделяют следующие виды этого заболевания:
1. Генитальная форма (эндометриоз яичников, матки, маточных труб, наружных половых органов, влагалища, ретроцервикальной области)
2. Экстрагенитальная форма (эндометриоз кишечника, мочевого пузыря, легких и др.)
3. Комбинированная форма
Эндометриоз: симптомы
В редких случаях эндометриоз может никак себя не проявлять, годами развиваясь в организме женщины. Однако чаще у пациентов с эндометриозом симптомы все же присутствуют и проявляются следующим образом:
1. Болевой синдром
При эндометриозе часто возникают болевые расстройства внизу живота или поясницы, которые особенно выражены за несколько дней до и во время менструации. Признаком эндометриоза также является сильная боль в области половых органов при половом акте, а также в прямой кишке при дефекации
2. Нарушение менструального цикла
Эндометриоидные клетки, находясь в непривычной для них среде, начинают проявлять себя так же, как в матке, то есть периодически «менструировать». Поэтому одним из признаков эндометриоза являются обильные менструации и кровотечения во время менструального цикла. Чаще всего коричневые мелкие выделения возникают за 1-3 дня до менструации или после нее — в течение 1-7 дней.
3. Бесплодие
Репродуктивная функция нарушена у 60% женщин с эндометриозом.
4. Симптомы интоксикации
Признаки эндометриоза, проявляющиеся на фоне сильного болевого синдрома, — это симптомы интоксикации: озноб, тошнота, рвота, повышение лейкоцитов в крови.
Причины заболевания:
В современной гинекологии нет единой версии происхождения эндометриоза. Причины этого заболевания, по мнению различных специалистов, кроются в следующем:
1. Ретроградная менструация
В некоторых случаях может случиться так, что менструальная кровь из матки попадает в маточные трубы, яичники или брюшную полость. Эта кровь обязательно содержит клетки эндометрия, которые при благоприятных обстоятельствах могут проникнуть в любой орган.
2.Гинекологические операции
Эндометриоз матки, яичников, маточных труб может возникнуть в результате гинекологических операций: прерывания беременности, кесарева сечения, удаления кисты, прижигания эрозии шейки матки и др.
3. Гормональная дисфункция
У женщин с эндометриозом часто наблюдается нарушение уровня гонадотропных и стероидных гормонов в крови.
4. Нарушение иммунитета
Состояние иммунологического состояния организма имеет большое значение в развитии болезни. В здоровом организме вероятность внедрения эндометриоидных клеток в необычные места их обычной локализации значительно снижается. Поэтому необходимо постоянно стремиться вести образ жизни, направленный на укрепление иммунной системы.
5. Наследственный фактор
Отмечено, что риск эндометриоза матки, яичников или других органов увеличивается примерно в 5 раз, если это заболевание обнаружено у близких родственников (сестер, мам).
Эндометриоз, симптомы и последствия которого не слишком выражены, на самом деле поддается медикаментозному или хирургическому лечению, после которого вероятность беременности увеличивается. При сильном поражении яичников, матки и маточных труб метод ЭКО более эффективен. Однако следует отметить, что эффективность процедуры ЭКО при запущенном эндометриозе, как правило, не превышает 25-30%.
Эндометриоз: можно ли забеременеть
Резюме
- Как эндометриоз матки и беременность влияют друг на друга?
- возможна ли беременность при эндометриозе?
- Экстракорпоральное оплодотворение и эндометриоз
- Донорство яйцеклеток
- Беременность как лечение эндометриоза
- Эндометриоз при беременности: риски
Эндометриоз — одна из самых частых причин нарушения репродуктивной функции у женщин. Согласно некоторым исследованиям, аномальное разрастание слизистой оболочки матки встречается примерно у половины пациенток с проблемами фертильности. Часто говорят, что эндометриоз и беременность абсолютно несовместимы, что при наличии этого заболевания невозможно зачать или иметь ребенка. Верно ли это мнение? Попробуем разобраться в этой статье.

Эндометриоз — это аномальное разрастание клеток эндометрия (слизистых оболочек) за пределы матки. При этом схожая по функциональности ткань образуется на разных органах в зависимости от локализации, в которой различают две формы заболевания:
- генитальные — эндометриоидная ткань находится внутри репродуктивных органов женщины (на яичниках, придатках, маточных трубах, влагалище и т д);
- экстрагенитальный — клетки эндометрия колонизируют пупок, кишечник, в некоторых случаях даже легкие.
Рост и развитие эндометрия во время менструального цикла контролируется половыми гормонами женщины. Аномально расположенные эндометриоидные клетки поддерживают эту зависимость и подвержены одним и тем же циклическим изменениям, включая рост и десквамацию, что проявляется в виде менструальных кровотечений. Патогенность данного заболевания заключается в том, что кровоточащие очаги эндометрия вызывают воспалительные процессы в окружающих органах и тканях, которые проявляются такими симптомами, как:
- Болезненные ощущения в месте локализации;
- Увеличение размеров пораженного органа;
- Бесплодие (при локализации патологии в репродуктивных органах).
Эта патология развивается преимущественно у женщин репродуктивного возраста (18-35 лет). Однако это также может произойти в подростковом возрасте (даже до начала менструации) и после наступления менопаузы.
Влияние беременности на эндометриоз и наоборот — доказанный медицинский факт. В медицинском сообществе считается, что зачатие и рождение ребенка не только снижает вероятность заболевания, но и позволяет вылечить его, когда оно уже сформировалось. В свою очередь, эндометриоз отрицательно влияет на беременность, но не обязательно делает ее невозможной или осложненной. Статистика показывает, что до 70% женщин с этим заболеванием могут зачать и родить здорового ребенка без осложнений. Главное условие для этого — сохранение проходимости маточных труб и отсутствие повреждения гонад, вырабатывающих гормоны, регулирующие овуляцию.
Возможна ли беременность при эндометриозе?
Как уже было сказано, наступление естественной беременности при эндометриозе возможно при сохранении функциональности гонад и маточных труб. Если заболевание находится в запущенной (хронической) стадии, может потребоваться операция по удалению лишней патологически разросшейся ткани, а также вызванных ею спаек, эндометриоидных кист. Рекомендуется попытаться зачать ребенка в течение первого года после операции, поскольку вероятность зачатия со временем уменьшается.
Дополнительными условиями для успешной беременности при эндометриозе яичника или матки являются:
- регулярное обследование у врача для проверки развития болезни, уровня половых гормонов в крови;
- отказаться от вредных привычек: курения, употребления алкоголя, психоактивных веществ;
- нормализация массы тела и режима питания;
- ограничить физическую активность, поддерживая определенную степень активности;
- ограничить влияние стрессовых ситуаций, неблагоприятной экологии, воздействия токсичных веществ, радиации и т д
Следовательно, беременность при эндометриозе возможна — патология хоть и несет определенные риски для репродуктивной функции женщины, тем не менее не исключает зачатия, успешного развития и рождения здорового ребенка. Однако в 30% случаев женщины, страдающие этим заболеванием, сталкиваются с невозможностью забеременеть естественным путем.
Экстракорпоральное оплодотворение и эндометриоз
Если в течение года активной половой жизни женщина, перенесшая операцию по устранению последствий эндометриоза, не смогла забеременеть, врач-репродуктолог после медицинского обследования диагностирует бесплодие. В этом случае экстракорпоральное оплодотворение может помочь ей стать мамой. Суть этого метода заключается в том, что процесс зачатия происходит не в организме будущей мамы, а в искусственном инкубаторе, где смешиваются яйцеклетки и сперма, ранее отобранные супружеской парой. При этом процедура проводится под полным контролем врачей, благодаря чему обеспечивает:
- снизить влияние патологий женской репродуктивной системы на выработку здоровых яиц;
- отбор наиболее жизненно важных ооцитов для оплодотворения, что снижает вероятность отторжения эмбриона или развития в нем врожденных аномалий.
Показаниями к назначению экстракорпорального оплодотворения при эндометриозе матки являются:
- поражение матки эндометриозом 3-4 степени;
- возраст женщины от 38 лет с эндометриозом 1-2 степени, с потенциально адекватным ответом на гормональную терапию;
- экстрагенитальный эндометриоз 4 степени с тяжелыми симптомами;
- недостаточная эффективность лечения в течение 2 лет, после чего вероятность естественной беременности становится низкой;
- после успешной медикаментозной терапии при низкой фертильности или ее отсутствии.
Экстракорпоральное оплодотворение назначает врач на основании анамнеза пациента и результатов предварительных диагностических исследований. Перед этим женщина проходит консультацию, на которой репродуктолог объясняет ей особенности этого метода лечения бесплодия, его преимущества и риски, а также назначает конкретную дату начала процедуры, выбирает дополнительные репродуктивные технологии для увеличения его эффективность и так далее
Донорство яйцеклеток
В некоторых случаях эндометриоз приводит к полной неспособности женского организма производить оплодотворенные яйцеклетки. Это делает невозможным естественное зачатие или ЭКО с использованием генетического материала пациента. Однако остальные его репродуктивные функции могут оставаться на нормальном уровне. В такой ситуации она может стать мамой с помощью донорских яйцеклеток ЭКО.
Показаниями к применению этого метода лечения при планировании беременности при эндометриозе являются:
- хроническая форма болезни в запущенной стадии;
- небольшой или полностью истощенный запас фертильных гамет в яичниках;
- плохое качество яиц пациента;
- затрудненный или невозможный доступ к фолликулам яичников из-за наличия плотных и насыщенных кровеносных сосудов с эндометриоидной тканью на них;
- травма ткани яичника в результате операции, в результате которой женский организм перестает вырабатывать высококачественные гаметы.
Для экстракорпорального оплодотворения с использованием донорских яйцеклеток отбирается генетический материал самого высокого качества. Пациент принимает непосредственное участие в выборе донора, так как его характеристики с большой вероятностью будут унаследованы от будущего ребенка. Женщина получает на руки карту донора, в которой указаны биометрические параметры, раса, возраст, национальность донора, его профессиональная деятельность, увлечения и другие характеристики.
Эндометриоз со временем может прогрессировать, ухудшая репродуктивную систему. Молодым женщинам, у которых это состояние находится на ранней стадии развития, во время ЭКО рекомендуется собрать несколько здоровых и зрелых яйцеклеток, часть из которых будет использована в текущих попытках, а остальные — в будущем, когда пациенты сами захотят иметь еще детей, но патологически развитый эндометрий нарушит функцию яичников.
Беременность как лечение эндометриоза
Многие врачи рассматривают беременность как один из способов профилактики и даже лечения данной патологии. Причин тому несколько: в период вынашивания у женщины меняется гормональный фон, подавляется секреция эстрогена яичниками. Эти гормоны способствуют развитию эндометрия во время первой фазы менструального цикла. В результате снижение их концентрации снижает вероятность гиперплазии (чрезмерного развития) слизистой оболочки матки. Подобный эффект оказывает и грудное вскармливание, при котором также снижается выработка эстрогенов, что предотвращает развитие эндометриоза.
Хотя определенный лечебно-профилактический эффект беременности на эндометриоз действительно существует, его нельзя считать эффективным методом лечения. Причина в том, что после родов гормональный фон женщины вернется на прежний уровень. Это спровоцирует появление новых очагов эндометриоза. К тому же риски беременности при данной патологии значительно превышают пользу.
Эндометриоз во время беременности: риски
Эндометрий играет решающую роль в наступлении и развитии беременности. Этот слизистый слой, покрывающий внутреннюю поверхность полости матки, обеспечивает прикрепление и питание эмбриона. Из-за патологических изменений эндометрия его функция может быть снижена или полностью отсутствовать. Из-за этого могут развиться следующие осложнения:
- самопроизвольный аборт в первом триместре — вероятность такого исхода у пациенток с эндометриозом на ранних сроках беременности на 76% выше, чем у здоровых женщин;
- внематочная (внематочная) беременность, связанная с имплантацией эмбриона в патологические участки эндометрия вне полости матки (чаще всего в маточных трубах, на яичнике);
- нарушение развития плаценты, вследствие чего возможна ее преждевременная отслойка при беременности или недостаточное питание и снабжение эмбриона кислородом;
- преэклампсия — комплекс патологических синдромов у беременных, в том числе повышение артериального давления и концентрации белка в моче);
- преждевременные роды — в этом случае малыша можно спасти, но для этого нужно поместить его в специальную палату для консервации;
- невозможность естественных родов из-за неправильного предлежания самого плода или плаценты (в этом случае помогает кесарево сечение).
Современная медицина позволяет пациентам даже с тяжелой стадией заболевания иметь значительные шансы на успешное зачатие, роды и роды. Для этого требуются некоторые меры со стороны самой пациентки — в частности, строгое соблюдение режима посещения врача для обследований, ограничения в питании, внимательное отношение к состоянию здоровья (не только репродуктивной функции), отказ от вредных привычек, тяжелая физическая работа, изнурительные психоэмоциональные нагрузки и др
Эндометриоз и бесплодие – проблемы современной женщины
Эндометриоз и бесплодие – проблемы современной женщины
Эндометриоз — одна из актуальных проблем современной медицины, остающаяся среди самых загадочных и трудно объяснимых заболеваний. Заболеваемость эндометриозом, по данным различных исследователей, колеблется от 12 до 50% у женщин репродуктивного возраста. По последним данным, во всем мире эндометриозом страдают около 176 миллионов женщин преимущественно репродуктивного возраста, каждая десятая. В России в структуре гинекологической патологии ПЭ занимает третье место (после воспалительных заболеваний и лейомиомы матки).
Частота выявления эндометриоза при лапароскопии, в том числе проводимых с целью выяснения причины бесплодия, составляет 20-55%. Более 30% пациентов, обращающихся в центры вспомогательных репродуктивных технологий для экстракорпорального оплодотворения, страдают наружным генитальным эндометриозом.
Патогенез эндометриоза
Согласно общепринятому определению, эндометриоз — это патологический процесс, который формируется на фоне нарушенного гормонального и иммунного гомеостаза и характеризуется ростом и развитием ткани, идентичной по структуре и функциям эндометрию, вне границ нормальной локализации эндометрия слизистая оболочка тела матки. Эндометриоз способен разрастаться путем инфильтрации в окружающие ткани и органы с их последующим разрушением. Эндометриоз также способен распространяться по кровеносным сосудам, то есть имеет способность метастазировать. Существует множество теорий о патогенезе эндометриоза. Среди них можно выделить шесть основных групп: транспортные (имплантация, трансплантация, иммиграция, лимфогенное, гематогенное и ятрогенное распространение); метапластический; эмбриональный; гормональный; иммунологический; генетический. Однако ни одно из представлений о происхождении эндометриоза не может объяснить ключевой момент в развитии болезни — имплантацию и превращение клетки эндометрия в эндометриоидный очаг. Очевидно, что этот процесс невозможен без определенных условий: регургитированные клетки эндометрия обладают повышенной способностью к выживанию, прилипанию, имплантации и пролиферации, и все эти процессы происходят на фоне активного неоангиогенеза. В то же время защитные факторы организма не могут обеспечить разрушение (апоптоз) эктопических клеток эндометрия. Реализация этих условий возможна под влиянием одного или нескольких факторов, сочетание которых может варьироваться неограниченно: генетическая предрасположенность, снижение местного и общего иммунитета, гормональный дисбаланс, нарушение метаболизма клеток эндометрия, нарушение ангиогенеза в системах, неблагоприятное влияние экология, воспаление, механическая травма. Большое значение имеют воспалительные процессы, нарушения иммунологического состояния и гормональной регуляции, а также генетические факторы.
Результаты многочисленных исследований показывают, что развитие и прогрессирование наружного генитального эндометриоза происходит на фоне нарушения иммунного баланса, а именно активации системы В-лимфоцитов с одновременным развитием Т-клеточного иммунодефицита образование очагов гетеротопии в результате воспалительного процесса, раздражения брюшины продуктами ретроградной менструации, воздействия инфекций (особенно вирусных), применения кортикостероидов, иммунодепрессантов, ионизирующего излучения, влияния других факторов окружающей среды и генетическая обусловленность. Цитокины и факторы роста имеют большое значение в патогенезе и гистогенезе ЭГЭ. Цитокины, которые являются пептидами-медиаторами, способствуют межклеточному взаимодействию и являются универсальными регуляторами воспаления. Их биологический потенциал заключается в регуляции взаимодействия макрофагов с элементами ткани, в образовании очагов воспаления и иммуномодуляции. Выявлено, что на системном уровне при ИГЭ наблюдается значительная продукция провоспалительных цитокинов — фактора некроза опухоли α (TNF-α) и интерлейкина-1r (IL-1R) (увеличение в 2-3 раза). Это указывает на хронический воспалительный процесс, при котором происходит снижение выработки лептина, который нейтрализует действие ингибиторов ароматазы Р450, вызывая их активацию, приводящую к патологическому увеличению синтеза эстрогенов. Важная роль в развитии ИГЭ отводится процессам апоптоза. Подавление апоптоза приводит к выживанию активных, биологически неадекватных клеток эндометрия, которые обычно удаляются во время менструального цикла. Гормоны — регуляторы апоптоза, действующие по всему телу. В поздней фазе фазы пролиферации экспрессия белка, ингибирующего апоптоз, BCL-2 (протоонкогена, который кодирует цитоплазматический и мембранный белок клеток, ингибирующих апоптоз) снижается в максимально возможной степени, что увеличивает самоуничтожение апоптоза клетки эндометрия, инфицированные вирусом и биологически неадекватные, в том числе с высоким пролиферативным потенциалом. В этом случае защитный апоптоз. Увеличение экспрессии BCL-2 и остановка апоптоза являются важным механизмом, лежащим в основе патогенеза эндометриоидных гетеротопий. Неоангиогенез является ключевым звеном в формировании и развитии различных форм эндометриоза, поскольку васкуляризация эндометриоидных имплантатов является одним из важнейших факторов их проникновения в окружающие ткани. Неоангиогенез — это фундаментальный процесс, обеспечивающий восстановление поврежденных тканей — завершающую стадию воспалительного процесса (разрастание и репарацию). Ангиогенез происходит за счет разветвления и пролиферации существующих сосудов или образования новых сосудов из стволовых клеток костного мозга. Последние называются «эндотелиальными клетками-предшественниками» (ECP).
Эндометриоз и бесплодие
Основные клинические проявления эндометриоза — боль и бесплодие. К болевому синдрому относятся: дисменорея, диспареуния, дисхезия, хроническая тазовая боль. Выраженность боли при эндометриозе зависит от локализации эндометриоидных гетеротопий, степени или стадии распространения процесса и поражения эндометриозом соседних органов, а также от длительности заболевания и индивидуальных особенностей пациентов.
Мнения специалистов об эндометриозе как причине бесплодия достаточно противоречивы, и если тяжелые формы действительно являются причиной бесплодия, то многие ученые не рассматривают начальные проявления болезни как фактор бесплодия. Потенциально спровоцировать субфертильность при аденомиозе могут следующие факторы: снижение рецептивности эндометрия из-за асептического воспаления, нарушение секреторной трансформации эндометрия. Инактивация сперматозоидов и повреждение эмбрионов перитонеальными макрофагами, чрезмерно повышающими свою активность под влиянием паракринных регуляторов и цитокинов, избыточно образующихся в очагах хронического воспаления, сопровождающего аденомиоз. Повышенная сократительная активность матки и динамическая закупорка маточных труб с нарушением их перистальтики, вызванные нарушениями метаболизма простагландинов в гетеротопических очагах. Сексуальная дисфункция из-за тяжелой диспареунии.
- D. Ziegler D, Borghese B., Chapron C в своих исследованиях в 2010 году наглядно показали, что эндометриоз поражает все органы репродуктивной системы: в первую очередь развиваются противовоспалительные изменения в фолликулярной жидкости, которые влияют на оогенез: удлиняется фолликулярная фаза , уменьшает размер доминантного фолликула, активация апоптоза кумулюсных клеток. В яичниках также развиваются выраженные изменения — снижение реакции яичников на контролируемую стимуляцию овуляции. Для достижения эффекта получения зрелых ооцитов требуются более высокие дозы GnRH / FSH / hMG.
Наиболее выраженные изменения развиваются в матке. Из-за снижения экспрессии молекул адгезии интегрина, L-селектина, эндометрия проповедуется за счет усиления синтеза простагландинов, нарушение регуляции экспрессии генов секреторной трансформации, в результате чего функция рецептора матки нарушается.
Лечения бесплодия, ассоциированного с эндометриозом
Хирургическое лечение бесплодия остается первой стадией бесплодия, связанного с эндометриозом.
Хирургическое лечение бесплодия, связанного с эндометриозом — прагматичный подход. (Паоло Верчеллини, Эдгарто Сомильяна, Паоло Вигано, Анналиса Аббьяти). Было проведено 14 РКИ, в которых было наглядно продемонстрировано, что кумулятивная частота наступления беременности при лапароскопическом лечении и удалении участков эндометриоза от 6 до 18 месяцев, беременность наступает в 50% случаев. У женщин с минимальным и легким эндометриозом (ASRM) лапароскопическая операция является эффективным методом увеличения частоты беременностей / живорождений по сравнению с диагностической лапароскопией. (Якобсон и др., 2010). Совокупный уровень самопроизвольных беременностей в течение 3 лет колеблется от 46% до 77% для умеренного эндометриоза и от 44% до 74% для тяжелого эндометриоза (Nezhat et al. 1989).
В ходе лапароскопии рассчитывается ряд показателей индекса фертильности эндометриоза (EFI), предложенных GD Adamson.
У женщин с бесплодием из-за эндометриоза, перенесших лапароскопическую операцию перед АРТ, врачи могут рассмотреть возможность полного хирургического удаления эндометриоидных поражений для повышения уровня живорождений (Opoien et al., 2011).
Обоснованность хирургического лечения до ЭКО.
Парное исследование случай-контроль (Garcia-Velasco et al. 2004). Удаление эндометриом перед ЭКО не улучшает фертильность.
Во главе бесплодия, связанного с эндометриозом, стоит яичниковый резерв и возможность рождения собственного генетического ребенка.
Мета-анализ Edgardo Somigliana et al. По результатам ЭКО / ИКСИ у женщин, прооперированных по поводу двусторонних эндометриом: количество антральных фолликулов и частота наступления беременности после лапароскопического удаления эндометриоидных кист яичников значительно снижаются.
Следует рекомендовать хирургическое вмешательство (Garcia-Velasco, 2009)
- для лечения сопутствующих болезненных симптомов;
- если невозможно достоверно исключить злокачественный процесс;
- при больших кистах.
Хирургическое удаление кист> 3-4 см:
- если есть возможность собрать все растущие фолликулы без нарушения целостности эндометриомы, то операция не требуется;
- при кистах меньшего размера, скрывающих растущие фолликулы (особенно при фиксированном яичнике), может потребоваться операция.
Гормональная терапия для лечения бесплодия при эндометриозе перед операцией
- Обзор Hughes et al. 2007 г на основе 18 РКИ
При оценке индивидуальных вариантов гормональной терапии, используемых для лечения боли, связанной с эндометриозом, результаты сравнения не выявили существенных различий в частоте живорождений с применением разных препаратов.
Рекомендации ESHRE (уровень A)
Женщинам, страдающим бесплодием из-за эндометриоза, врачи не должны назначать гормональную терапию перед операцией для подавления функции яичников с целью улучшения фертильности (Hughes et al., 2007).
Лекарства после операции
- Мета-анализ Adamson GD, Pasta DG, 1995, 14 РКИ: «Послеоперационное лечение бесполезно или вредно».
- Фернесс С., Яп К., Чеонг Ю.С., 2004.
8 РКИ (n = 420) — применение гормональной терапии в послеоперационном периоде: увеличения частоты наступления беременности не наблюдалось.
Рекомендации ESHRE (уровень A)
Женщинам с бесплодием, вызванным эндометриозом, врачи не должны назначать сопутствующую гормональную терапию после операции для улучшения показателей спонтанной беременности (Furness et al., 2004).
Согласно ESHRE (2014), хотя адъювантная гормональная терапия не должна назначаться женщинам с бесплодием, связанным с эндометриозом, до или после операции в ожидании АРТ при наличии боли, врачи не должны воздерживаться от использования такой терапии . Все гормональные препараты блокируют овуляцию в течение всего времени их приема, поэтому их применение женщинам, планирующим беременность, нецелесообразно. Тем не менее, гормональная терапия широко используется для контроля боли и предотвращения прогрессирования и рецидива эндометриоза, что позволяет женщине сохранить фертильность и после ее отмены успешно забеременеть при условии правильного выбора времени терапии и желаемого препарата. («переходная терапия»).
Стимуляция яичников с помощью внутриматочной инсеминации может использоваться только у пациентов с хорошим прогнозом с легким или умеренным эндометриозом как единственным диагностированным фактором снижения фертильности. Согласно рекомендациям ESHRE (2014), у женщин с эндометриозом I / II стадии по классификации AFS / ASRM может рассматриваться контролируемая стимуляция яичников с внутриматочной инсеминацией в течение 6 месяцев после хирургического лечения, а уровень клинической беременности аналогичен бесплодие неизвестного происхождения.
Подавление лекарств до вспомогательных репродуктивных технологий (ВРТ): агонисты гонадолиберина. Как свидетельствуют результаты метаанализа трех рандомизированных контролируемых исследований (РКИ), использование a-GnRH у женщин с эндометриозом II — IV стадии в течение 3-6 месяцев до начала АРТ привело к значительному увеличению частоты беременностей. В то же время доза гонадотропина, использованная в следующем цикле, была сопоставима с контролем, однако наблюдалась статистическая неоднородность (16) уровня техники. Рождаемость у этих женщин также была выше.
Рекомендации ESHRE (2014 г.), основанные на данных систематических обзоров и метаанализов, по ведению женщин с эндометриозом и бесплодием, которые согласуются с российскими клиническими рекомендациями по эндометриозу (2013 г.)
- Гормональная терапия (КОК, прогестаген, GnRH-a или даназол) для подавления функции яичников не должна назначаться для улучшения фертильности у пациентов с эндометриозом и бесплодием (уровень доказательности рекомендация A) [Hughes E, et al. Кокрановская база данных Syst Rev 2007: CD000155].
- У женщин с эндометриозом I / II стадии и бесплодием по AFS / ASRM следует проводить не только диагностические, но и терапевтические (иссечение или аблацию эндометриоидных очагов), включая разделение спаек, чтобы увеличить частоту наступления беременности (уровень доказательности рекомендаций A) [Якобсон Т.З и др. кокрановская база данных Syst Rev 2010: CD001398].
- В случае хирургического лечения эндометриомы у бесплодных пациенток следует проводить удаление капсулы кисты, а не дренирование или электрокоагуляцию стенки кисты, чтобы увеличить общую частоту спонтанной беременности (уровень доказательности, рекомендация A) [Hart RJ, et al. Кокрановская база данных Syst Rev 2008: CD004992].
- У женщин с эндометриозом III / IV стадии по AFS / ASRM и бесплодием следует рассмотреть возможность хирургической лапароскопии, а не лечения (уровень доказательности B).
- У женщин с эндометриозом I / II стадии AFS / ASRM, контролируемая стимуляция яичников с внутриматочной инсеминацией может рассматриваться вместо ожидаемого лечения для увеличения частоты наступления беременности.
- У женщин с эндометриозом I / II стадии в соответствии с классификацией AFS / ASRM можно рассмотреть возможность контролируемой стимуляции яичников с помощью внутриматочной инсеминации в течение 6 месяцев после хирургического лечения, в то время как частота клинической беременности аналогична таковой при бесплодии неизвестного происхождения (уровень доказательности рекомендаций: C).
- Использование GnRH-a в течение 3-6 месяцев до процедуры ВРТ увеличивает вероятность клинической беременности в 4 раза (уровень доказательности, рекомендация B) [Sallam HN, et al. Кокрановская база данных Syst Rev 2006: CD004635].
Подводя итог, необходимо сказать, что актуальность проблемы эндометриоза и особенно бесплодия не вызывает сомнений, равно как и то, что решение многих проблем еще далеко не завершено, что требует дальнейших исследований.